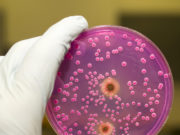
Анализ посев на микоплазму

Герпес: причины, симптомы, и лечение вируса
«Простуда» на губах знакома практически каждому. Стоит подхватить насморк или перенервничать, как тут же появляется неприятный предвестник – покалывание где-нибудь у рта.
Вирус простого герпеса...
Как оформить ДМС для сотрудников?
ДМС для сотрудников или добровольное медицинское страхование (ДМС) персонала сегодня является важной частью социального пакета и корпоративной культуры компании. ДМС — это эффективный инструмент...
Как частно нужно проверять зрение?
Каждый должен время от времени проверять свои глаза. Проверка зрения — важная составляющая здоровья глаз. Но как часто на самом деле следует проверять ваши...
Как проходит лечение зубов у детей во сне?
Лечение зубов у детей во сне проводиться с использованием общего наркоза. Что к такому лечению прибегают, когда ребенок маленький или слишком беспокоен, боится. Хороший...
Как проходит консультация проктолога?
Проктолог – это узкопрофильный медицинский специалист, специализирующийся на лечении болезней проктологического типа. Кроме этого, врач проктолог осуществляет диагностику и профилактику заболеваний, которые связаны с...
Чем занимается эстетическая стоматология?
Сегодня одной из развивающихся областей стоматологии является эстетическая стоматология, которая занимается улучшением внешнего вида зубов и улыбки. Она объединяет в себе большое разнообразие процедур...
Анализ посев на микоплазму
Микоплазмы представляют собой бактерии, которые способны вызывать различные инфекции у человека и животных. Анализ посева на микоплазму – это один из методов лабораторной диагностики,...